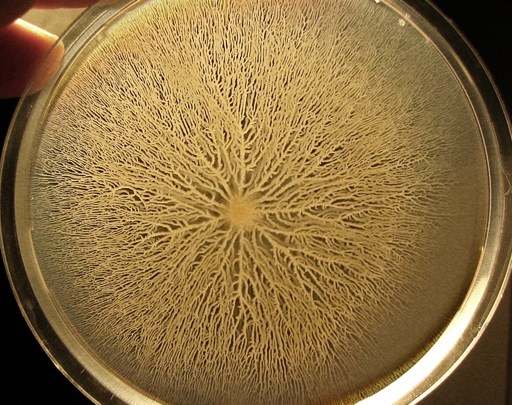

Search
Robby Berman
Contributing Writer
I’m a writer, musician, and father living in central New York with my wife, two daughters, one dog, two cats, and countless questions. I’m especially interested in animal rights, creativity, politics, the nature of things and time, and in making a worthwhile contribution. You can follow me @everyrobby.
Read Less

University of California, Davis researchers announce the disappointing results of their implantation of human stem cells in pigs.

Neuroscientist David Linden says the human need for love is actually the indirect result of our inefficient neurons.